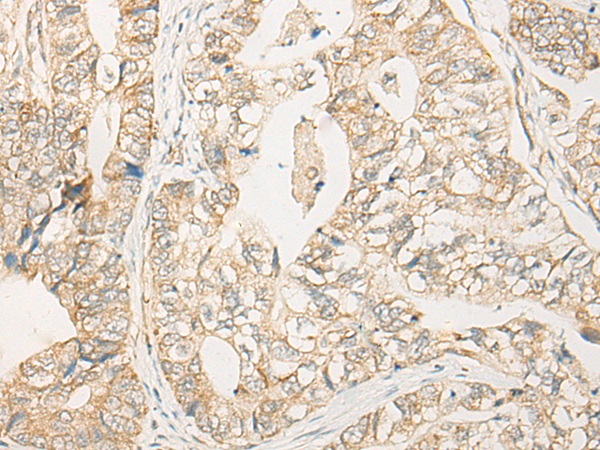

|
Background: |
Eukaryotic translation initiation factor 2 (EIF-2) functions in the early steps of protein synthesis by forming a ternary complex with GTP and initiator tRNA and binding to a 40S ribosomal subunit. EIF-2 is composed of three subunits, alpha, beta, and gamma, with the protein encoded by this gene representing the beta subunit. The beta subunit catalyzes the exchange of GDP for GTP, which recycles the EIF-2 complex for another round of initiation. Multiple transcript variants encoding different isoforms have been found for this gene. |
|
Applications: |
ELISA, IHC |
|
Name of antibody: |
EIF2S2 |
|
Immunogen: |
Fusion protein of human EIF2S2 |
|
Full name: |
eukaryotic translation initiation factor 2 subunit beta |
|
Synonyms: |
EIF2; EIF2B; PPP1R67; EIF2beta; eIF-2-beta |
|
SwissProt: |
P20042 |
|
ELISA Recommended dilution: |
5000-10000 |
|
IHC positive control: |
Human gastric cancer; |
|
IHC Recommend dilution: |
30-150 |
購物車
購物車 幫助
幫助
 021-54845833/15800441009
021-54845833/15800441009
